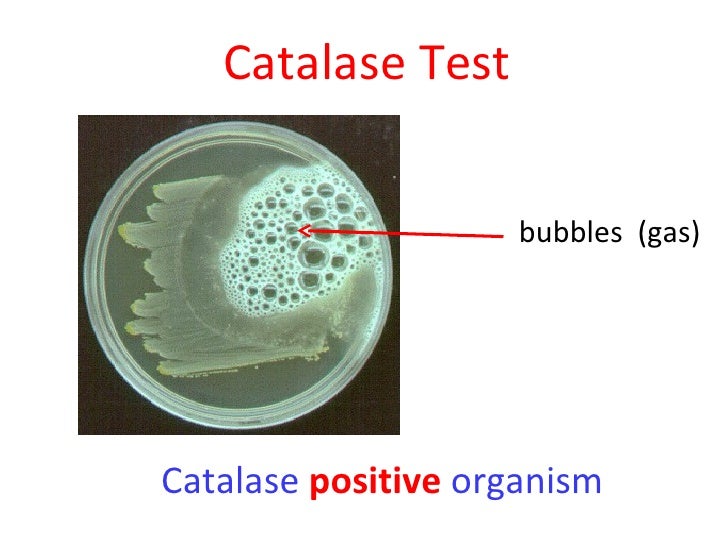

Biochemical Tests For Escherichia coli (E. coli) Bacteriology Notes - Coli onto a substance containing h2o2. No gas bubble is produced. Coli from other bacterial species. If bubbles appear, it’s like a. Scientists have devised a clever test to reveal e. You should also read this: Bmv Ohio Test

Catalase test (Principle, Procedure, Result interpretation and - On nutrient agar, escherichia coli (e. Observe the reaction of the bacterial culture and catalase reagent. If catalase is present, bubbles of oxygen gas will be produced, indicating a positive test result. They simply drop a tiny bit of e. Catalase test is one of the three most important tests used for the identification and differentiation of bacterial species in. You should also read this: Tennessee Hazmat Test

Catalase Test Negative - Biochemical tests are commonly used to identify and characterize bacteria, including escherichia coli (e. Immediate gas bubble production is seen due to the release of oxygen. The catalase test is a fundamental tool in microbiology, essential for distinguishing bacterial species and aiding clinical diagnostics. If catalase is present, bubbles of oxygen gas will be produced, indicating a positive test result.. You should also read this: Bmw E90 2ef8 Thermostat Test

The result of biochemical test for E.coli Download Scientific Diagram - Understanding how to interpret your results accurately is crucial for effective diagnosis and identification of bacterial species. Immediate gas bubble production is seen due to the release of oxygen. The result and interpretation of catalase test is as follows: Interpreting results from the catalase test. Because of variation in incubation time, size of inoculum and variable skill in the experimenter,. You should also read this: Most Test Run Scorers

Biochemical tests used for identification of Escherichia coli. 67 - With that caution, familiarize yourself with these. Scientists have devised a clever test to reveal e. Immediate gas bubble production is seen due to the release of oxygen. Catalase is an enzyme produced by bacteria to detoxify hydrogen peroxide (h2o2) into water (h2o) and oxygen (o2) gas. Coli from other bacterial species. You should also read this: Bd Veritor Covid Test

Laboratory identification of Escherichia coli (E.coli) with biochemical - This simple assay detects the presence of the. Coli from other bacterial species. With that caution, familiarize yourself with these. Catalase is an enzyme produced by bacteria to detoxify hydrogen peroxide (h2o2) into water (h2o) and oxygen (o2) gas. The result and interpretation of catalase test is as follows: You should also read this: C.r.a.p. Test
Diff mediasv - On nutrient agar, escherichia coli (e. Understanding how to interpret your results accurately is crucial for effective diagnosis and identification of bacterial species. The catalase test is a fundamental tool in microbiology, essential for distinguishing bacterial species and aiding clinical diagnostics. Because of variation in incubation time, size of inoculum and variable skill in the experimenter, results for each species. You should also read this: Do Hobby Lobby Drug Test

Test for identification of E. coli and fecal coliform Download - If bubbles appear, it’s like a. They simply drop a tiny bit of e. Observe the reaction of the bacterial culture and catalase reagent. Because of variation in incubation time, size of inoculum and variable skill in the experimenter, results for each species may be slightly different. If catalase is present, bubbles of oxygen gas will be produced, indicating a. You should also read this: Immunodeficiency Genetic Test

SOLVED Bacterium NA plate Catalase reaction Catalase reaction Bubbles - Observe the reaction of the bacterial culture and catalase reagent. If bubbles appear, it’s like a. Scientists have devised a clever test to reveal e. Interpreting results from the catalase test. The result and interpretation of catalase test is as follows: You should also read this: Wilson Hardness Tester

Biochemical tests for identification of Gram negative bacteria - With that caution, familiarize yourself with these. Coli catalase test provides insight into the organism’s enzymatic capabilities, helping microbiologists distinguish e. No gas bubble is produced. Because of variation in incubation time, size of inoculum and variable skill in the experimenter, results for each species may be slightly different. On nutrient agar, escherichia coli (e. You should also read this: Braintree Driving Test